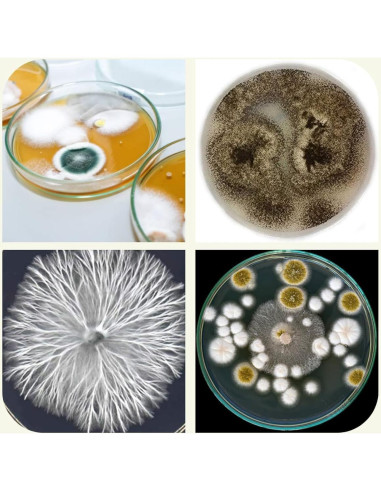
Placas de Agar de Dextrosa de Papa EZ BioResearch - 10 Unidades

El Agar de Dextrosa de Papa (PDA) se utiliza para el cultivo de levaduras, mohos y hongos. El Agar de Dextrosa de Papa está compuesto de Infusión de Papa deshidratada, Dextrosa y Agar. La Infusión de Papa y la Dextrosa sirven como base nutricionalmente rica que permite un crecimiento fúngico robusto. El agar sirve como agente solidificante. Las placas de PDA prevertidas están listas para usar. No se necesita pesar polvo, mezclar ni esterilizar.
Características destacadas
- Las placas de PDA prevertidas están listas para usar, muy convenientes para cultivar hongos.
Especificaciones técnicas
- Fabricante: EZ BioResearch LLC
- Está descontinuado por el fabricante: No
- Peso: 0.45 kg
- Dimensiones: Ancho: 21.65 cm, Alto: 13.68 cm, Profundidad: 13.53 cm